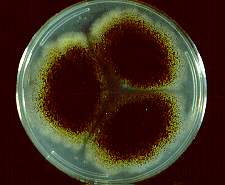

|
|
Descripción de las Micosis
superficiales Oportunistas
Candidiasis o candidosis:
  
Comisura labial Pliegue submamario
Pene
La Candida es un hongo levaduriforme
perteneciente a la flora normal del organismo humano pero que en
ciertas situaciones de desventaja del ser humano puede multiplicarse
y provocar lesión. Estas situaciones de desventaja serían los
factores predisponentes para sufrir infecciones por agentes
oportunistas como son labilidad del sistema inmunológico, factores
mecánicos como roce o fricción, factores metabólicos como diabetes,
entre otros, algunas condiciones fisiológicas como edades extremas
de la vida, embarazo etc, que le proporcionan al hongo las
condiciones adecuadas para su multiplicación y producción de la
lesión.
Definición:
La Candidiasis superficial es una enfermedad
producida por Candida albicans, especie relacionada con mayor
frecuencia con esta enfermedad, la cual forma parte de la flora
normal del humano, ante la presencia de factores predisponentes como
diabetes mellitus, obesidad, mal nutrición, entre otros aprovecha la
oportunidad para producir la lesión característica que puede afectar
tanto piel como mucosas, pero puede presentarse también
generalizada.
Epidemiología:
La Candidiasis puede ocurrir en todas las
edades, en ambos sexos. Se presenta en personas que tienen
alteración de las defensas inmunológicas ya sea como resultado de
enfermedad de base como diabetes mellitus, por ejemplo, también en
otras situaciones como tratamientos con inmunosupresores,
tumoraciones malignas, trastornos de las barreras naturales (piel y
mucosas), aprovechando la situación debilitada del huésped para
transformarse en patógenos y pueden provocar infecciones muy graves.
Manifestación clínica:
La Candidiasis superficial puede afectar
tanto piel o mucosas. Las lesiones de piel intertrigo caracterizada
por presentarse en los pliegues cutáneos como por ejemplo (
inguinal, submamario), observándose una lesión eritematosa, húmeda,
de bordes bien delimitados, en la mucosa oral, se van a observar
lesiones blanquecinas que se manifiestan como úlceras pequeñas,
dolorosas, denominadas muguet, también pueden observarse lesiones
relacionadas con el área genital como vulvovaginitis en la mujer, en
la cual se presenta un flujo blanquecino, lechoso, puede presentar
prurito, y lesiones en la piel por rascado, en el hombre puede
observarse inflamación del glande por factores como higiene
deficiente, maceración, prepucio largo y angosto, caracterizado por
vesículas muy pequeñas con un contenido blanco cremoso, con una base eritematosa, y maceración. Además las uñas también pueden afectarse
produciendo onicomicosis no dermatofitica, produciendo opacidad de
la lámina ungueal, inflamación periungueal.
Diagnóstico:
Se toma muestra de la lesión que puede ser
por raspado, por hisopado si es una lesión húmeda, se procede a
realizar examen directo con Hidróxido de sodio o de potasio al 10-20
% y tinta Parker apreciándose al microscopio levaduras en ocasiones
con brotes, pseudohifas. Se cultiva en agar Sabouraud, o Lactrimel,
se deja en condiciones ambientales y se va a observar un crecimiento
a las 24-48 horas mostrando colonias planas, color claro, húmedas,
las cuales se vuelven a cultivar en Bilis agar para evidenciar al
observarlo las clamidosporas estructuras características de la
especie Candida albicans, sino se logra esta identificación
deben realizarse pruebas bioquímicas como asimilación y fermentación
de azúcares, entre otras que van a orientar hacia la especie que
está afectando a ese paciente.


Cultivo de Candida albicans Formación de tubo
germinal

Formación de Clamidosporas estructura
que identifica Candida albicans
Otomicosis

Examen con otoscopio de
Conducto auditivo externo
 
Membrana del tímpano afectada Toma de muestra con
hisopo
Definición: Es una infección producida por hongos que
aprovechan la presencia de de algunos factores y nutrientes
requeridos por estos agentes etiológicos en el conducto auditivo
externo, para permitirles su crecimiento como son proteínas,
carbohidratos, humedad, temperatura y pH adecuado, que puede ser
aguda, subaguda, o crónica que afecta el epitelio escamoso del
conducto auditivo externo.
Epidemiología:
En general se considera que las otitis
externas son motivo de consulta en un 5-20 %, y de estas 15 a 20 %
son atribuidas a los hongos, las infecciones mixtas son raras porque
los hongos suelen inhibir a las bacterias. Es de distribución
mundial, se considera más frecuente en adultos.
Manifestación clínica: Se manifiesta generalmente con prurito,
dolor, descamación del epitelio, en ocasiones el paciente manifiesta
hipoacusia relacionada con la formación de un tapón de hifas,
cerumen y restos epiteliales.
Diagnóstico:
Comienza con la sospecha clínica, luego se
realiza la toma de muestra previa limpieza de las áreas externas del
conducto auditivo externo, lo cual permite la recolección de escamas
o secreción presentes en el área afectada, se prepara para el examen
directo con hidróxido de sodio o potasio al 10-20 %, y se
procede a observar con el microscopio óptico con un aumento de 10X,
y se pueden observar estructuras como hifas hialinas, gruesas,
segmentadas, cuando se trata del género Aspergillus por
ejemplo, y en el caso de Candida se observan blastosporas y
pseudohifas.


Cultivo de Aspergillus níger
Conidióforo de Aspergillus níger
Queratomicosis

Lesión corneal
Definición: Es una enfermedad producida por hongos generalmente
oportunistas (Aspergilus, Fusarium, Candida), que pueden
afectar al globo ocular y a las partes blandas que lo rodean. El
mecanismo de infección puede darse por diferentes vías como por
ejemplo desde el exterior en el caso de una conjuntivitis,
queratitis, infección de las vías lagrimales, desde estructuras
vecinas infectadas, pueden ser introducidos por heridas perforantes
(ramas de árbol, hojas, madera, vidrio), o durante el acto
operatorio (extracción de cataratas), diseminación por vía
hematógena. La estructura afectada con más frecuencia es la córnea,
en la cual se producen procesos supurativos, ulcerosos, que pueden
provocar opacidad progresiva irreversible.
Epidemiología: Generalmente existe un factor predisponerte que
permite la invasión de estos agentes oportunistas por lo tanto el
diagnóstico se relaciona con todas aquellas personas que presenten
alguno de los factores predisponentes.
Manifestación clínica: Las manifestaciones clínicas son similares a
pesar de las diversas especies descritas como agentes etiológicos,
sin embargo las infecciones por levaduras suelen ser menos
virulentas que los hongos filamentosos, la lesión en la gran mayoría
de los casos tienen como antecedente un traumatismo el cual provoca
una sintomatología de cuerpo extraño, con ardor, visión borrosa,
dolor, fotofobia, evolucionando progresivamente hacia una úlcera,
con infiltrado alrededor, y opacidad.
Diagnóstico:
Se realiza toma de la muestra en el sitio de lesión
(úlcera corneal), preferiblemente debe ser tomada por el oftalmólogo
del borde de la misma, se prepara el examen directo con KOH al 10 -
20 %, o coloración de Giemsa, tratando de observar las estructuras
fúngicas, se cultiva en medio de Sabouraud, Agar sangre, caldo
infusión cerebro corazón, y se coloca a temperatura ambiente hasta
37 °C, se observa un crecimiento tipo moho de color blanco
algodonoso.

Cultivo de Fusarium

Conidias de Fusarium en cultivo |